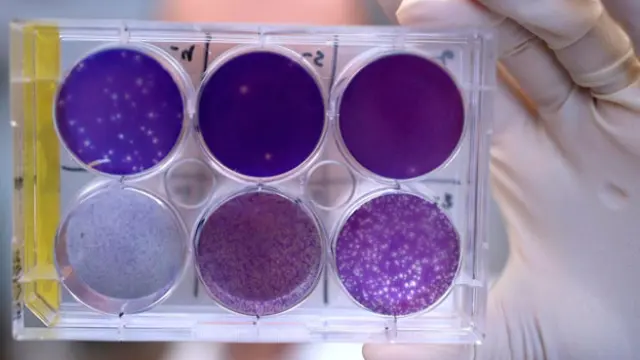

Identifican un anticuerpo que protege al feto del virus Zika
Científicos estadounidenses han identificado un anticuerpo humano que evita la infección en los fetos de ratón y reducir los niveles de virus en adultos.
La consecuencia más preocupante del virus Zika es que provoca el desarrollo de microcefalia en los fetos que son infectados. Ahora, un equipo de investigadores de la Escuela de Medicina de la Universidad de Washington, en colaboración con la Escuela de Medicina de la Universidad de Vanderbilt, ha llevado a cabo un avance que podría prevenir este problema de salud en los bebés, así como proteger a los adultos de la enfermedad.
Los científicos han efectuado un estudio en ratones en el que han podido identificar un anticuerpo humano que protege a los fetos de la infección del Zika, impidiendo además que la placenta sufra daños. También se ha observado que la molécula evita que los ejemplares adultos se contagien.
Para llevar a cabo el ensayo, el equipo examinó 29 anticuerpos anti-Zika de personas que se habían recuperado de la infección. Encontraron uno, llamado ZIKV-117, que demostró su eficacia para neutralizar cinco cepas de Zika, una muestra que representa a la diversidad del virus en todo el mundo.
Con la finalidad de comprobar que el anticuerpo puede proteger también a los animales vivos, los investigadores se lo administraron a ratones gestantes un día antes o bien un día después de que fueran infectadas. En ambos casos, el tratamiento redujo notablemente los niveles de virus en las hembras embarazadas y en sus fetos, así como en las placentas, en comparación con los ejemplares que no recibieron el anticuerpo.
Sueltan mosquitos macho mutantes en Brasil para combatir el Zika
Además, los resultados también revelaron que el anticuerpo protege a los ratones macho adultos contra una dosis letal del virus, incluso cuando se administra cinco días después del contagio inicial. "Estos anticuerpos naturales aislados de humanos representan la primera intervención médica que previene la infección del Zika y los daños a los fetos", afirma James Crowe, uno de los autores del estudio.
La investigación se encuentra en sus primeras fases y todavía queda mucho trabajo por delante para probar la eficacia del anticuerpo en humanos, pero los resultados son muy prometedores para llegar a un tratamiento que evite la microcefalia provocada por el Zika.